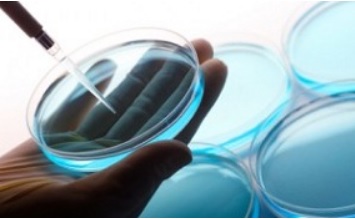

6月22日,江苏省质监局发布配装眼镜抽检结果。配装眼镜是矫正屈光不正的一种工具,主要由眼镜零售企业加工生产。此次共抽查产品186批次,合格176批次,合格率为94.6%。
抽查发现,6批次产品的球镜顶焦度项目不合格、1批次产品的柱镜顶焦度项目不合格。球镜顶焦度偏差、柱镜顶焦度偏差反映镜片基本光度特性,也是其矫正视力的功能指标。球镜顶焦度偏差和柱镜顶焦度偏差较大相当于加大或减少了患者的屈光度,造成所配眼镜的顶焦度和患者所需屈光度不符合,使患者眼睛长期处于欠矫或者过矫状态,产生视疲劳。
抽查中,2批次产品的光学中心水平偏差项目不合格、2批次产品的光学中心单侧水平偏差项目不合格,配戴时会在眼前产生棱镜效应,导致眼睛产生斜视或造成其他功能性损害。其中,光学中心水平偏差是光学中心水平距离的实测值与标称值(瞳距)的差值,光学中心单侧水平偏差是光学中心水平单侧距离的实测值与标称值(单侧瞳距)的差值。
此外,1批次产品的柱镜轴位偏差项目不合格。该项目是处方矫正眼睛散光的必要项目,直接关系到视力矫正及佩戴效果。偏差过大,会造成眼镜柱镜(即散光)轴位的方向与配镜者的柱镜(散光)轴位不重合,视物时出现重影等现象。还有1批次产品的装配质量项目不过关,眼镜存在明显隙缝,会导致产品使用寿命降低,并影响产品的美观和舒适度。
质监部门建议消费者选购时,选择有资质的验配店。查看验配店有没有营业执照等必要证件,有无必要验光配镜环境,验光师、定配工有无相应职业证书资质。注意眼镜架和眼镜片质量,查看镜片、镜架是否获取并加贴“QS”质量安全标志,外包装是否有合格证、厂名厂址、联系电话、执行标准等信息;镜片实物应表面光洁、透视清晰、色泽均匀、没有疵点和明显划痕;镜架电镀层应光亮,表面应无皱褶、无腐蚀点和变色等。
质量好的眼镜佩戴后应看的清楚、舒适、长久。眼镜装配、调整好后,可戴上眼镜走一走,看看远、近景,是否有头晕、恶心、眼痛以及看地面是否平坦、固定物有无倾斜等现象。佩戴中如出现头晕,眼花,流眼泪等视觉疲劳现象,应及时摘下眼镜去室外休息,在排除眼部疾病,不良用眼习惯等因素后,应及时检查配装眼镜是否存在质量问题。




